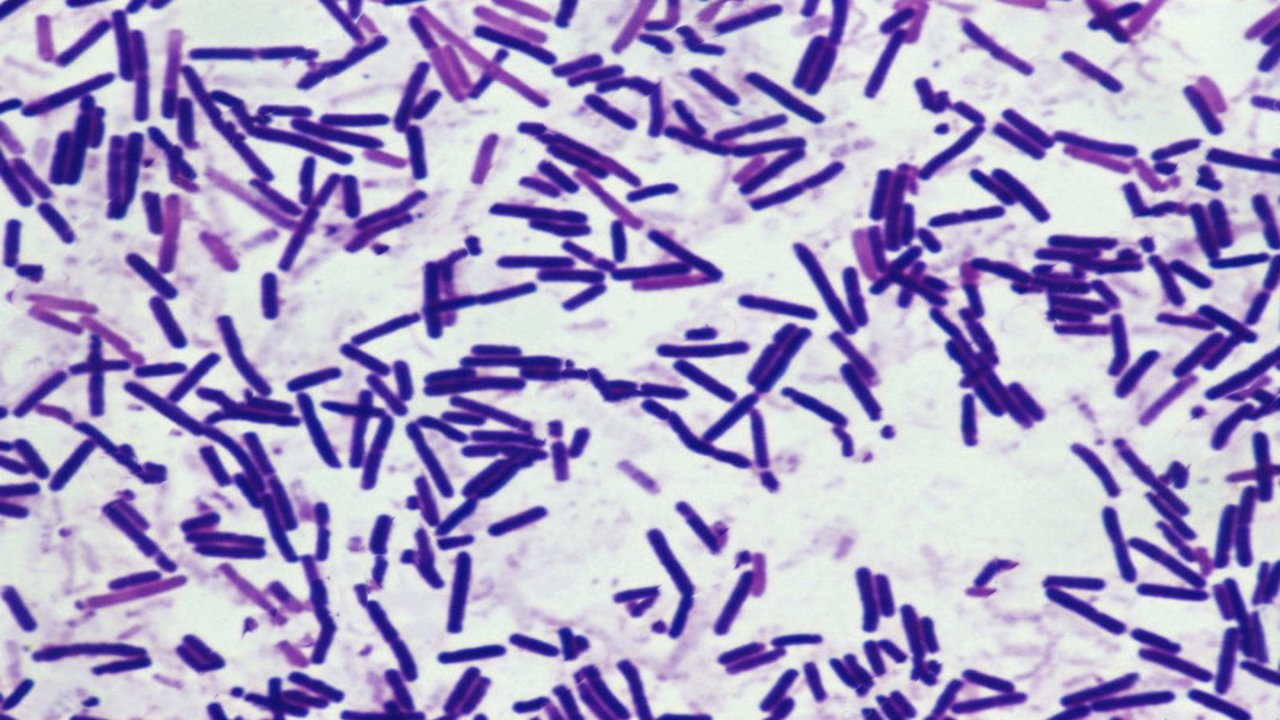
پاورپوینت باسیل های گرم- اسپورزا-باسیلوس ها و کلستریدیوم ها

-
 قیمت: 108٬000 تومان - دسته بندی فایل: پاورپوینت
قیمت: 108٬000 تومان - دسته بندی فایل: پاورپوینتپاورپوینت تاریخچه سیستم عامل های مایکروسافت و بررسی آنها
فروش ویژه پاورپوینت حرفه ای تاریخچه سیستم عامل های مایکروسافت و بررسی آنها باتخفیف استثنایی فقط 103هزارتومان تعداداسلاید.67اسلایدکامل
-
 قیمت: 88٬000 تومان - دسته بندی فایل: پاورپوینت
قیمت: 88٬000 تومان - دسته بندی فایل: پاورپوینتپاورپوینت بیمه حمل ونقل کالا (باربری)
فروش ویژه پاورپوینت حرفه ای بیمه حمل ونقل کالا (باربری) باتخفیف استثنایی فقط92 هزارتومان تعداداسلاید.53اسلایدکامل
-
 قیمت: 88٬000 تومان - دسته بندی فایل: پاورپوینت
قیمت: 88٬000 تومان - دسته بندی فایل: پاورپوینتپاورپوینت بـهـداشـت مـحـیـط کـار
فروش ویژه پاورپوینت حرفه ای بـهـداشـت مـحـیـط کـار باتخفیف استثنایی فقط92هزارتومان تعداداسلاید.48اسلایدکامل
-
 قیمت: 78٬000 تومان - دسته بندی فایل: پاورپوینت
قیمت: 78٬000 تومان - دسته بندی فایل: پاورپوینتپاورپوینت برنامه ملی خود مراقبتی و سفیر سلامت
فروش ویژه پاورپوینت حرفه ای برنامه خود مراقبتی و سفیر سلامت باتخفیف استثنایی فقط92هزارتومان تعداداسلاید.43اسلایدکامل
-
 قیمت: 32٬000 تومان - دسته بندی فایل: پاورپوینت
قیمت: 32٬000 تومان - دسته بندی فایل: پاورپوینتپاورپوینت اهداف توسعه کشاورزی پایدار
فروش ویژه پاورپوینت حرفه ای اهداف توسعه کشاورزی پایدار باتخفیف استثنایی فقط 69هزارتومان تعداداسلاید.12اسلایدکامل
-
 قیمت: 78٬000 تومان - دسته بندی فایل: پاورپوینت
قیمت: 78٬000 تومان - دسته بندی فایل: پاورپوینتپاورپوینت اصول طراحی ماشین های الکتریکی
فروش ویژه پاورپوینت حرفه ای اصول طراحی ماشین های الکتریکی باتخفیف استثنایی فقط92هزارتومان تعداداسلاید.43اسلایدکامل
-
 قیمت: 156٬000 تومان - دسته بندی فایل: پاورپوینت
قیمت: 156٬000 تومان - دسته بندی فایل: پاورپوینتپاورپوینت آشنایی مختصر با آناتومی و فیزیولوژی پوست و بررسی شناخت بیمار مبتلا به اختلالات پوستی
فروش ویژه پاورپوینت حرفه ای آشنایی مختصر با آناتومی و فیزیولوژی پوست و بررسی شناخت بیمار مبتلا به اختلالات پوستی باتخفیف استثنایی فقط123هزارتومان تعداداسلاید.116اسلایدکامل
-
 قیمت: 52٬000 تومان - دسته بندی فایل: پاورپوینت
قیمت: 52٬000 تومان - دسته بندی فایل: پاورپوینتپاورپوینت معرفی پارکینگ های شهری
فروش ویژه پاورپوینت حرفه ای معرفی پارکینگ های شهری با تخفیف استثنایی فقط 62453 هزار تومان تعداد اسلاید : 26 اسلاید
-
قیمت: 32٬000 تومان - دسته بندی فایل: پاورپوینت
قیمت: 32٬000 تومان - دسته بندی فایل: پاورپوینتپاورپوینت باسیل های گرم- اسپورزا-باسیلوس ها و کلستریدیوم ها
فروش ویژه پاورپوینت حرفه ای باسیل های گرم- اسپورزا-باسیلوس ها و کلستریدیوم هابا تخفیف استثنایی فقط 48681 هزار تومان تعداد اسلاید: 13 اسلاید
-
 قیمت: 32٬000 تومان - دسته بندی فایل: پاورپوینت
قیمت: 32٬000 تومان - دسته بندی فایل: پاورپوینتپاورپوینت DVT ترمبوز وریدی
فروش ویژه پاورپوینت حرفه ای DVT ترمبوز وریدی با تخفیف استثنایی فقط 39 هزار تومان تعداد اسلاید: 15 اسلاید
-
 قیمت: 32٬000 تومان - دسته بندی فایل: پاورپوینت
قیمت: 32٬000 تومان - دسته بندی فایل: پاورپوینتپاورپوینت مدیریت چهار نسل در سازمان های ایران
فروش ویژه پاورپوینت حرفه ای یک با تخفیف استثنایی فقط 48681 هزار تومان تعداد اسلاید: 15 اسلاید
-
 قیمت: 32٬000 تومان - دسته بندی فایل: پاورپوینت
قیمت: 32٬000 تومان - دسته بندی فایل: پاورپوینتپاورپوینت تاثیر جهانی شدن در توسعه کشور ها
فروش ویژه پاورپوینت حرفه ای تاثیر جهانی شدن در توسعه کشور ها با تخفیف استثنایی فقط 48681 هزار تومان تعداد اسلاید: 26 اسلاید
-
 قیمت: 88٬000 تومان - دسته بندی فایل: پاورپوینت
قیمت: 88٬000 تومان - دسته بندی فایل: پاورپوینتپاورپوینت آسیب شناسی ماهواره
فروش ویژه پاورپوینت حرفه ای آسیب شناسی ماهواره با تخفیف استثنایی فقط 82225 هزار تومان تعداد اسلاید: 50 اسلاید
-
 قیمت: 88٬000 تومان - دسته بندی فایل: پاورپوینت
قیمت: 88٬000 تومان - دسته بندی فایل: پاورپوینتپاورپوینت بخش دوم علوم تجربی سوم راهنمایی زمین زیستگاه ما
پاورپوینت بخش دوم علوم تجربی سوم راهنمایی زمین زیستگاه ما - زمین زیستگاه ما بخش دوم علوم تجربی سوم راهنمایی Skip فهرست مطالب 1-سرگذش...
-
 قیمت: 20٬000 تومان - دسته بندی فایل: پاورپوینت
قیمت: 20٬000 تومان - دسته بندی فایل: پاورپوینتمخارج تامین مالی
مخارج تامین مالی - استاندارد حسابداري شماره 13 حسابداري مخارج تامين مالي 1 هدف هدف اين استاندارد، تجويز نحوه عمل حسابداري مخارج تامين مالي اس...
-
 قیمت: 20٬000 تومان - دسته بندی فایل: پاورپوینت
قیمت: 20٬000 تومان - دسته بندی فایل: پاورپوینتكم ابياري
كم ابياري - فیزیولوژی تکمیلی کم آبیاری Deficit irrigation استاد: دکتر عبدی توسط: عبدا... عزیزیان زمستان 1385 محدوديت منابع آب، تزايد جمعي...
-
 قیمت: 25٬000 تومان - دسته بندی فایل: پاورپوینت
قیمت: 25٬000 تومان - دسته بندی فایل: پاورپوینتفرایند تحلیل سلسله مراتبیAHP
فرایند تحلیل سلسله مراتبیAHP - AHP فرایند تحلیل سلسله مراتبی پیشگفتار یکی از کارآمد ترین تکنیک های تصمیم گیری فرایند تحلیل سلسله مراتبی ( Ana...
-
 قیمت: 18٬000 تومان - دسته بندی فایل: پاورپوینت
قیمت: 18٬000 تومان - دسته بندی فایل: پاورپوینتفيزيك جامد
فيزيك جامد -سمینار درس فیزیک جدید موضوع: فیزیک حالت جامد- ابررسانا 2 فهرست 1- تاریخچه فیزیک حالت جامد 2- فیزیک حالت جامد ...
-
 قیمت: 24٬000 تومان - دسته بندی فایل: پاورپوینت
قیمت: 24٬000 تومان - دسته بندی فایل: پاورپوینتفشرده سازی صوت
فشرده سازی صوت - عنوان ارائه : فشرده سازی صوت ارائه دهنده : سید مجید طباطبایی زیر نظر استاد راهنما : جناب آقای حاجی میرزا بهار 86 فشرده س...
-
 قیمت: 25٬000 تومان - دسته بندی فایل: پاورپوینت
قیمت: 25٬000 تومان - دسته بندی فایل: پاورپوینتفعالیت بدنی و سلامت
فعالیت بدنی و سلامت - فعالیت بدنی و سلامت این سخنرانی از طرف گروه Supercourse به بازیهای المپیک آتن، یونان 29-13 آگوست 2004 ، تقدیم می شود. اه...
- صفحه نخست
-
دسته بندی ها
- فنی مهندسی
- علوم پزشکی
- علوم انسانی
-
عمومی
- کتاب
- وب و برنامه نویسی
- نرم افزار
- پاورپوینت
- علوم پایه
- نمونه سوال
- پرسشنامه
- گزارش تخصصی
- طرح کارآفرینی
- مقاله ترجمه شده
- تم و قالب
- موبایل و فایل فلش
- گرافیک
- فیلم و انیمیشن
- کنکور
- فرم و مستندات
- تحقیق دانش آموزی
- کارآموزی
- گوناگون و متفرقه
- نمونه سوال
- طرح درس
- اقدام پژوهی
- مبانی نظری و پیشینه تحقیق
- طرح درس
- طرح جابر
- فایلهای گرافیکی
- حل المسائل
- فرمول تولید مواد
- لپ تاپ
- تحقیق
- درباره ما
- راهنمای خرید
- پیگیری خرید
- گارانتی خرید



